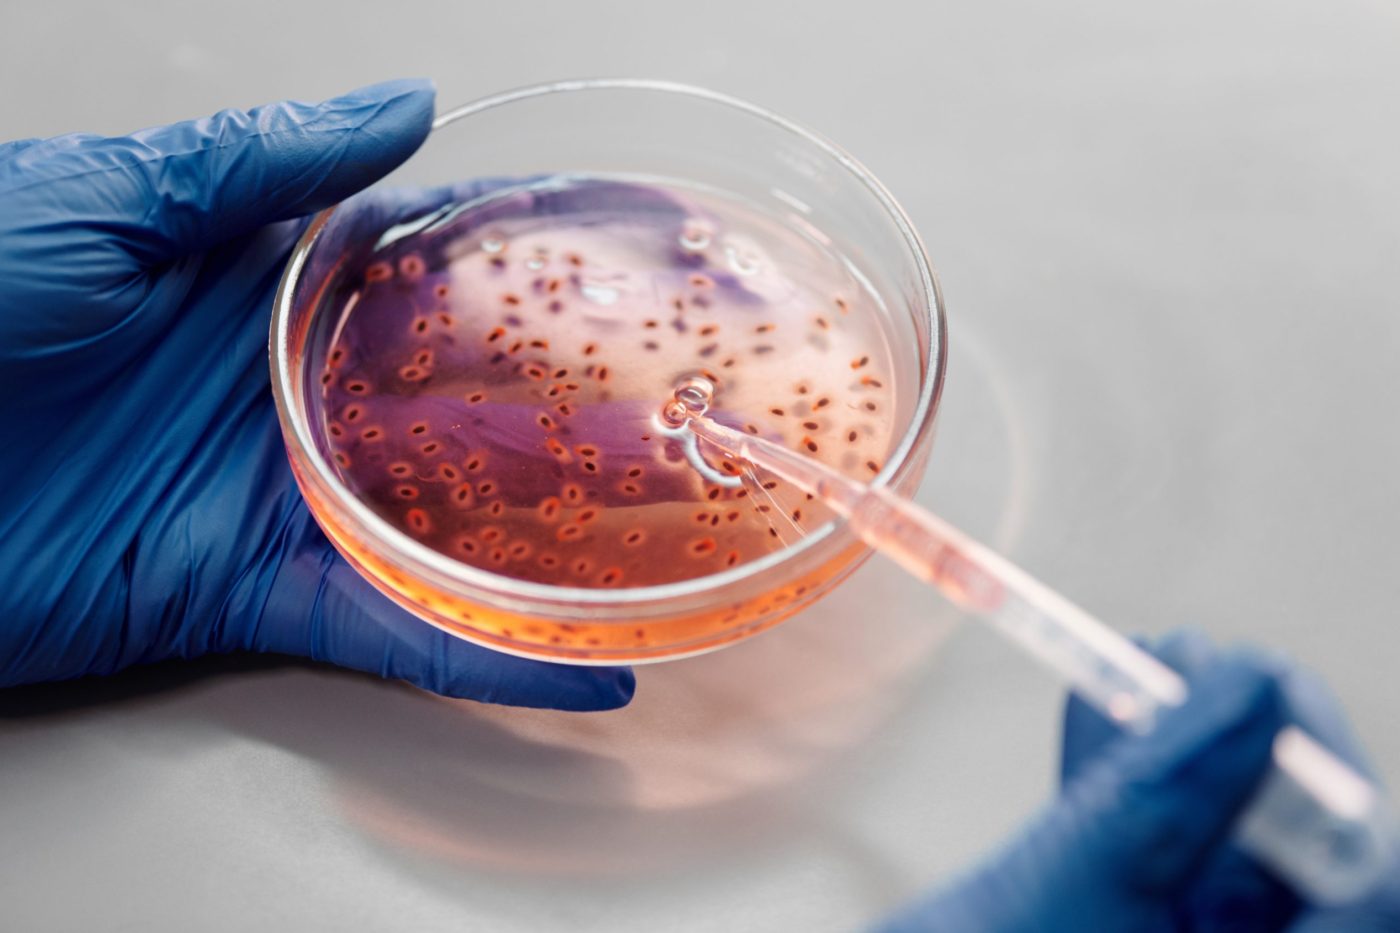

急に体を痒がり出して、どうしちゃったのかしら?
気付いたら、背中の毛がポコポコ抜けてるわ!
お腹に赤いボツボツがいっぱい出てきたわ!
これらの症状は、ワンちゃんの皮膚病で最も多い「膿皮症」です。
ヒトのニキビに似たボツボツにも見えます。

原因は皮膚の常在菌=ブドウ球菌種です。
この菌が毛穴や皮膚表面で異常増殖し、いろいろな毒素を産生することで皮膚が傷害を受けます。
赤くなったり、痒くなったり、皮膚が剥けたり。
この菌は健康なワンちゃんの皮膚や粘膜に常に存在しているので、本来はそれほど悪者ではありません。
しかし、ワンちゃんの皮膚は薄くて分泌腺が発達し、皮膚表面pHが高いので、ちょっとしたことがキッカケで菌が増えやすく、トラブルになりやすい動物と言えます。
例えば、高温多湿な環境、何かの理由で免疫力が低下した時、間違ったスキンケアなどが発症要因となります。

治療はまず外用療法から。
菌が原因なので、“殺菌”です。
殺菌系シャンプーや毛孔のクレンジング剤などによるスキンケアはとても大切です。
そして局所的な問題なら、殺菌ローションや軟膏、クリームなどで対応します。
次に全身性抗菌療法。
病変が広く深い場合は、全身性に抗菌薬を投与します。
つまり、内服薬を飲んでもらいます。
膿皮症を治療する際に、気を付けていることが2つあります。
ひとつは・・・
もし膿皮症を何度も繰り返しているのなら、膿皮症そのものは表に見えている問題で、その裏に別の根本的な問題があるかもしれない、と考えること。
なぜなら、膿皮症を引き起こす細菌は、常在菌だからです。
一緒に共存できる菌が悪さをするような環境になっている=つまり、皮膚そのものが問題である、ということ。
よくある問題は、アトピー性皮膚炎。
皮膚のバリア機能がとても弱いので、菌に負けてしまうのです。
アトピーではないけれど・・・という子は乾燥肌(ドライスキン)なことが多いですね。
フードが合わない場合もあります。
またヨークシャテリアに多い多汗症も原因となります。
ふたつ目は・・・
一般的な膿皮症の治療(抗菌療法)に反応しない場合、悪さをしている細菌が問題だ、ということ。
つまり、その菌は“多剤耐性菌”かも、ということです。
多剤耐性菌とは、通常処方する抗菌剤が全然効かない菌ということです。
なんとも恐ろしいことですが、近年問題になっています。
この場合、感受性試験をして、どの抗菌剤なら効果があるか、を調べないといけません。
ワンちゃんの皮膚病で最もよく遭遇する「膿皮症」ですが、その背景に常に気を配りながら治療にあたらないといけません。
高温多湿な時期は、特に注意しましょうね。

大学卒業後、川崎市の動物病院に勤務。 その後、日本動物高度医療センター画像診断科にて11年勤務。超音波検査を専門とする。 2018年 ガリレオ動物病院勤務。



